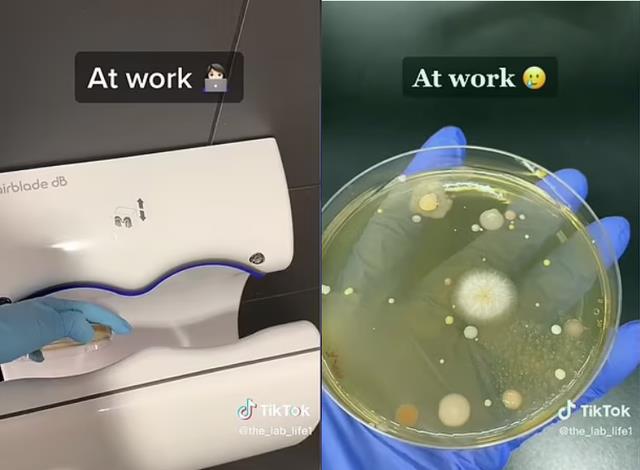
澳媒公布恐怖照片! 警告上厕所千万别碰这个， 狂喷致命病毒
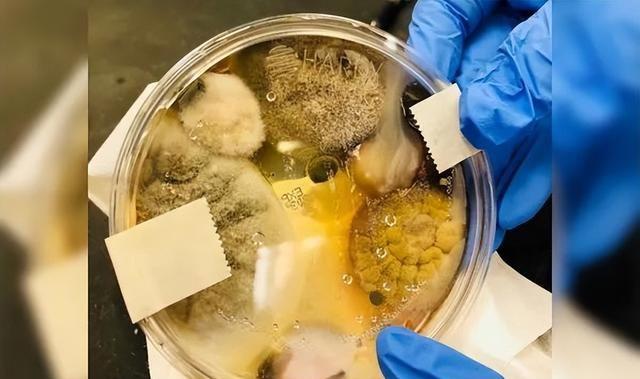
澳媒公布恐怖照片! 警告上厕所千万别碰这个， 狂喷致命病毒

澳媒公布恐怖照片警告上厕所千万别碰这个 狂喷致命病毒
澳媒公布恐怖照片警告上厕所千万别碰这个 狂喷致命病毒
//前言//
便后洗手是大家从小就有的卫生习惯,洗完手,把手烘干,仿佛就和厕所的浊物脱离了关系,可以清爽地离开了,不带走一片云彩。
但是,一个致命步骤就会让你的手白洗了,你洗过的手,甚至比你没洗过的手还脏!
#01:
科学家最新实验:
烘手机肮脏的秘密!
大家是否记得,洗手的步骤是什么呢?
一般来说,洗手的步骤可以简化为湿,搓,冲,捧,擦几个阶段,


而在最后的擦这一步,现在的人们一般都会放弃用纸巾,更多的使用烘手机。


然而,
烘手机虽然看似方便,
甚至比擦手的纸巾还要干净,
但你知道吗?
你用的烘手机,
其实才是弄脏你的手的元凶!


可能很多人都没想过,烘手机竟然隐藏着一个肮脏的小秘密:它能吸收空气中的细菌,然后把它们喷到刚洗过的手上。
最近,一个发布在TikTok上的实验,揭示了这个惊人的真相!
视频中,科学家从一家购物中心、一家电影院的烘干机以及她工作的地方在不同的培养皿上采集了样本。

在培育样本后,她发现所有三个样本都含有粘稠的、冒泡的生物。
而这个实验的对照组,是在厕所中挥舞之后的培养皿,实验结果显示这是唯一一个没有被细菌感染的样本。



News.com.au:这个女人的试验会让你不再想去使用烘手机


7 News:这个女人的脸书图片让你不再想使用烘手机


Daily Mail:不要在这些东西里再烘干你的手:女科学家揭示了干手机带来大量细菌的事实!
这位女科学家名叫Nicole Ward,主攻领域是护理学。


某一天,她突然突发奇想:总说卫生间里的马桶和水池很脏,那么烘手机呢?于是,她萌生出了一个测验烘手机内细菌的想法。
说干就干。
Nicole随意走进一个超市的公共卫生间,将培养细菌的器皿放入烘手机内三分钟,进行细菌采样。
48小时后,结果却让人大吃一惊!

上图就是培养皿放置48小时后,大量的细菌开始滋生,而且这些培养皿中的生长出来的细菌不是别的,正是致病菌和真菌!
致病菌和真菌是什么?
致病菌和真菌都有可能引发多种疾病。
例如检测出的克雷伯氏菌,可能会引起发热,恶心,呕吐;
而其中发现的阴沟肠杆菌,可能导致严重的呼吸道感染!


Nichole Ward不由得大吃一惊!她以为自己采样洗手间的烘手机只是心血来潮,然而就是这意外的突发奇想,却让她揭露了卫生间里不为人知的黑暗面!
第二次试验:烘手机甚至不如自然风干!
第二次,Nicole再次来到一个公共卫生间,根据日常的洗手环节洗完手后,右手选择伸入了公共卫生间的烘手机,左手选择了放在空气中自然晾干。
完成这一切后,为了避免影响,Nicole还专门戴上了隔离手套,等到回到无菌的实验室后,才用一次性涂抹棒分别在左、右手表面擦拭取样,随后放入新的培养皿中。
放置48小时后,Nichole 拿出了两组培养皿,对里面的细菌进行了检测。


结果,却让她再次吃了一惊!
在公共卫生间采到的样本中,用烘手机干手后,手部菌落数量为50cfu/g,而自然晾干后手部菌落数量仅为30cfu/g!
也就是说,用烘手机干手后,手部菌落数量比自然晾干增加了67%!
而第二次,第三次,结果也是如出一辙!用烘手机烘干后的手上的细菌菌落,比自然烘干的手部菌落数量多至少28%!


#03:
早已被公开的秘密,
这类烘手机更易滋生细菌
早在2014年,英国利兹大学医学院的研究员就发现,吹风式烘手机机漂浮的细菌,较手纸附近含菌量高出27倍,
在使用机器干手15秒后,即使超过5分钟,仍然可以在烘手机附近收集到大量细菌,
而与此同时,他们还发现,现在越来越多使用的新一代强风式烘手机,所含的细菌比暖风式烘手机更容易滋生细菌,细菌数量达27倍!


换句话说,烘手机真的可能会传播细菌!


而Nicole认为,之所以烘手机里会有这么多的细菌菌落,关键点在于烘手机里的过滤网。
按理说,过滤网这种东西,应该一周应该清理一次;然而在公众厕所,保洁员可能会尽职尽责地每隔数小时就清理一次马桶和水池,却没有人专门拆开烘手机清理过滤网,
长此以来,就造成了细菌的滋生。
更别提,像是一些强风式烘手机本来就有沟壑,更容易导致细菌滋生了。


有人拍摄的强风式烘干机底部,
当然,Nicole的这些科学实验,如今已经被强制删帖,因为许多烘手机品牌已经预备告她诽谤,说她有故意误导人不使用烘手机的嫌疑!
有的烘手机品牌表示他们的烘手机绝对卫生,医院都在使用。
针对这些质疑,Nichole虽然不得不删除了自己的研究成果,但还是耿直地回应:
如果如烘手机厂商所说,烘手机是干净的,那么为什么有那么多的细菌?
Nichole称,
整个实验过程没有意外,微生物一旦开始孵化,就会扩大到这个地步,你用烘手机干手后,它们就在你手上,只是肉眼不可见。
另外,Nichole 还给了些使用烘手机时的建议:很简单,随身携带湿巾就可以!


随身携带纸巾,不仅可以保证纸巾的干净,更能够直接避免接触这些脏脏的烘手机,比自然风干更干净,更不用说直接去触碰公共设施那些很可能携带致命病菌的烘手机和纸巾了!
最后
无论如何,
为了您的健康,
以后在外头,
还是少使用烘手机为好…
使用纸巾或者自然风干,
都是更加安全和健康的方法。
-

- 北纬30度线附近还有许多怪异的现象你知道哪些
-
2025-04-04 09:34:11
-
- 十大被诅咒的家族
-
2025-04-04 09:31:56
-

- 巴士灵异事件 揭示375巴士灵异事件 的细节
-
2025-04-04 09:29:41
-

- 世界上最好的小狗 世界上最好的小狗是什么狗
-
2025-04-04 09:27:26
-

- 2007年,广西鬼楼半夜怪叫11年,兄弟低价购入,抓鬼赚翻
-
2025-04-04 02:09:55
-

- 7款全球最贵葡萄酒,你都喝过?
-
2025-04-04 02:07:40
-
- 10种很火却没用的东西 有钱也别乱买 尤其是第一个
-
2025-04-04 02:05:25
-

- 假如远见卓识的康熙传位于他,清朝很可能成为超级大国,八国联军不是威胁
-
2025-04-04 02:03:10
-

- 你说 三星堆究竟咋回事
-
2025-04-04 02:00:56
-

- 犯罪型大脑真的存在吗?
-
2025-04-04 01:58:41
-
- 多年来 一直无法被人们破解的6个神秘事件真相 是
-
2025-04-04 01:56:26
-

- 全球车圈纯电豪华第一股,路特斯的想象空间有多大?
-
2025-04-04 01:54:11
-

- 安徽强奸恶魔戴庆成大案侦破纪实:作案上百次强奸116人
-
2025-04-04 01:51:57
-

- 北京375路公交车灵异事件 其
-
2025-04-04 01:49:41
-

- 什么茶杯最值钱又好看,探索世界上最值钱且美丽的茶杯
-
2025-04-03 18:41:19
-

- 中国女首富的谜团 国内面板行业的现状
-
2025-04-03 18:39:04
-
- 大案纪实:谈了两个男朋友接连遭遇意外身亡
-
2025-04-03 18:36:50
-
- 时空隧道还是人类骗局揭开百慕大三角未解之谜,科考队给出关键证据
-
2025-04-03 18:34:35
-
- 中国也有巨石阵神秘的史前石棚下 先民们究竟想表达什么
-
2025-04-03 18:32:20
-

- 详细介绍俄罗斯T系列坦克,曾经的钢铁洪流让对手闻风丧胆!
-
2025-04-03 18:30:05



 中国发现最大的蛇,在2000年的四川出现五十米巨蟒
中国发现最大的蛇,在2000年的四川出现五十米巨蟒 中国十大土豪身价(中国十大土豪身价排名)
中国十大土豪身价(中国十大土豪身价排名)